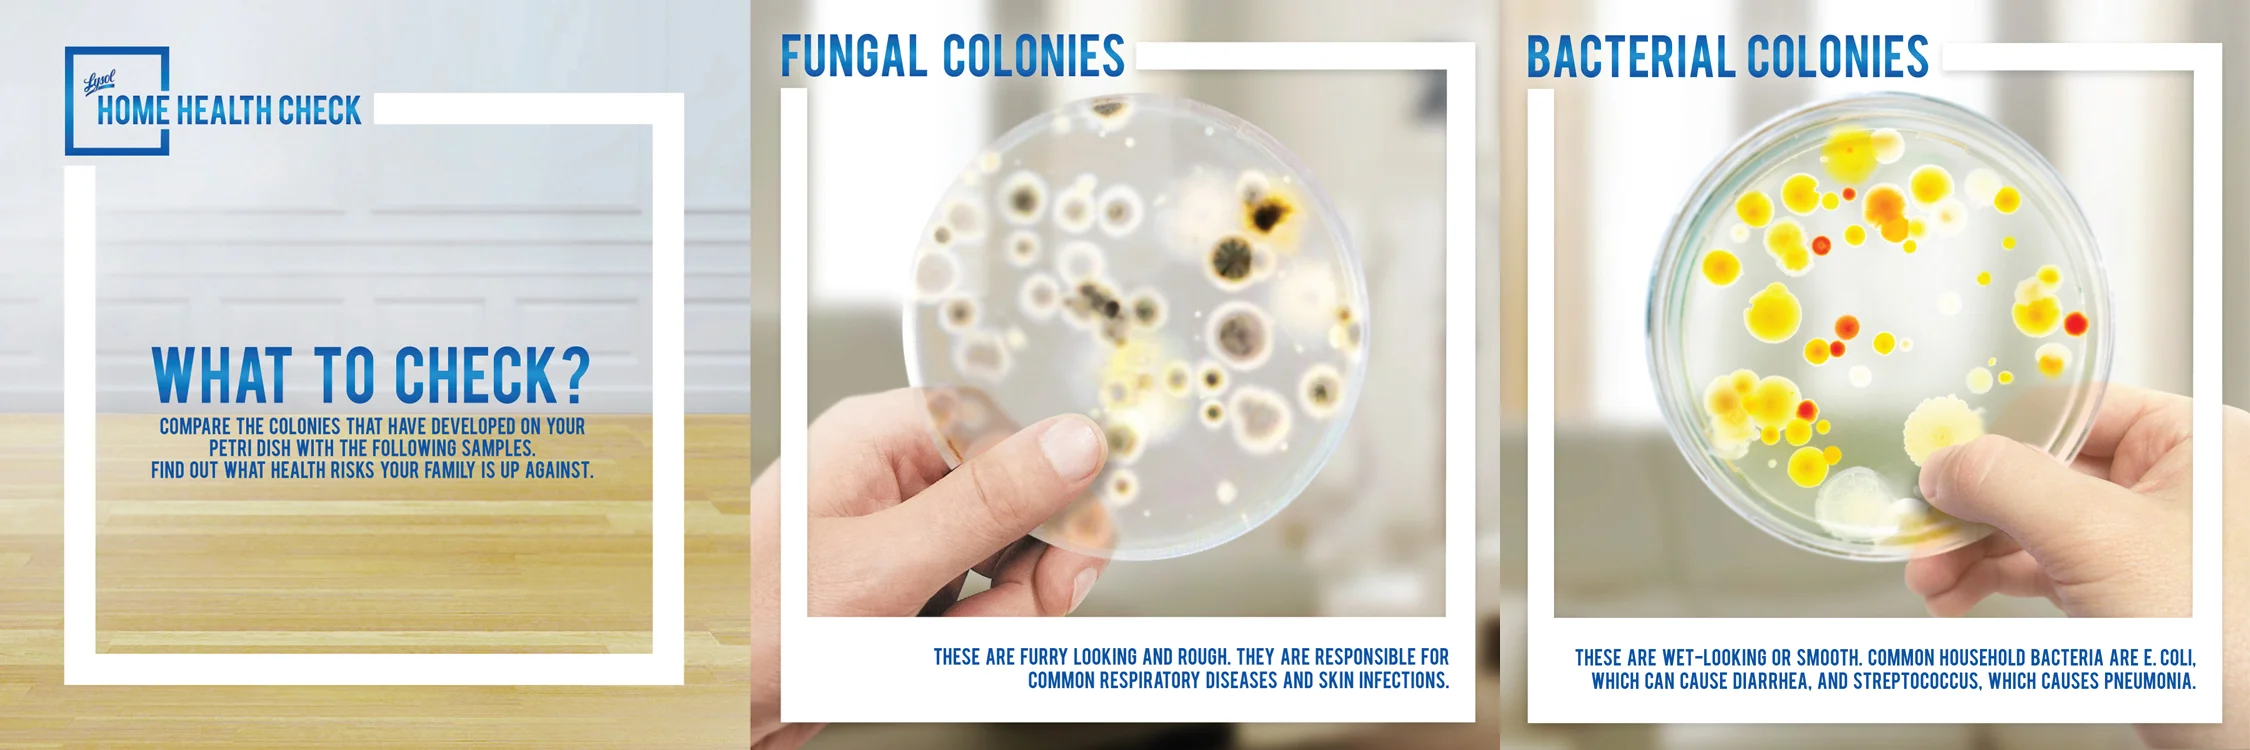

HEALTH & HUMAN CARE
Work that spanned the spectrum from healthcare to human care during my tenure as the leader of McCann Health. In this this exciting role, I worked with prestigious clients such as J&J One Touch, Nestlé NAN Infant Nutrition, Nestlé Nestogen, Nestlé Nido, Abbott, Galderma Benzac & Cetaphil, Betadine, and Lysol among others.
Lysol Home Health Check
Core Creative Idea

Lysol Home Health Kit
Lysol Ambient Materials
Lysol “Two In One”
Core Creative Idea

Lysol “Two In One” Executions
LYSOL “HEALTHY HOME RATIO”
Core Creative Idea
Lysol “Healthy Home Ratio” Executions
J&J One Touch Blue Circle Idea & Tool Kit
J&J One Touch Blue Circle Lecture Modules
J&J One Touch Blue Circle Magazine Executions
J&J One Touch Blue Circle Posters
ABOTT
BETADINE
BENZAC
NESTLE CHUCKIE
NIDO
NESTLE NESTOGEN